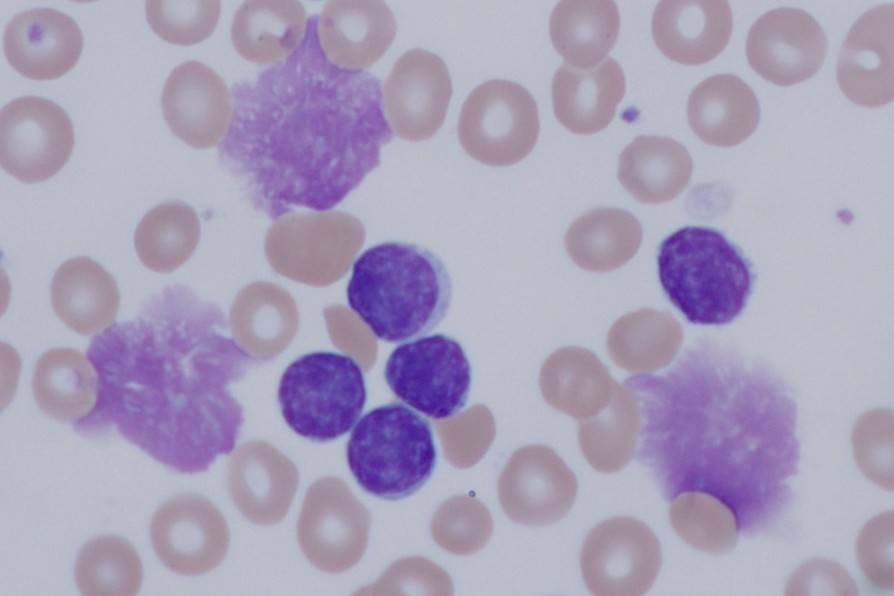

Sie befinden sich hier
Inhalt
13.12.2025 |
Beginn:
09:00
Uhr
11. Update Innere Medizin 2025
Ort: Hörsaal 1, Haus 6, Ebene 4, Theodor-Kutzer-Ufer 1-3, 68167 MannheimFORTBILDUNGSPUNKTE
16.12.2025 |
Beginn:
18:00
Uhr
Viszeralmedizinische Kolloquien: "Gastrointestinal Stroma Tumore (GIST) - Diagnostik und Therapie"
Ort: Online-VeranstaltungFORTBILDUNGSPUNKTE
17.12.2025 |
Beginn:
14:30
Uhr
Stillcafé
Ort: Haus 43 (Patientenhaus), Raum 22, Theodor-Kutzer-Ufer 1-3, 68167 Mannheim
17.12.2025 |
Beginn:
16:30
Uhr
10. MCC Kolloquium: Kinderonkologie
Ort: Online-Veranstaltung
18.12.2025 |
Beginn:
15:15
Uhr
Antrittsvorlesung Dr. Daniela Heidenreich im Rahmen des Habilitationsverfahrens
Ort: Hörsaal 1, Haus 6, Ebene 4, Theodor-Kutzer-Ufer 1-3, 68167 Mannheim
18.12.2025 |
Beginn:
16:30
Uhr
Organspende Webinar: "Inspiring change: what we can learn from leading nations in organ donation"
Ort: Online-VeranstaltungFORTBILDUNGSPUNKTE
19.12.2025 |
Beginn:
16:15
Uhr
Antrittsvorlesung Dr. André Luckscheiter im Rahmen des Habilitationsverfahrens
Ort: Alte Brauerei, Hörsaal 2, Röntgenstraße 7, 68167 Mannheim
06.01.2026 |
Beginn:
10:00
Uhr
Die UMM auf dem Neujahrsempfang 2026
Ort: Congress Center Rosengarten, Rosengartenplatz 2, 68161 Mannheim
14.01.2026 |
Beginn:
17:00
Uhr
Post-ASH 2025 - Highlights des Jahrestreffens der „American Society of Hematology”
Ort: Hörsaal 1, Haus 6, Ebene 4, Theodor-Kutzer-Ufer 1-3, 68167 MannheimFORTBILDUNGSPUNKTE
16.01.2026 |
Beginn:
16:15
Uhr